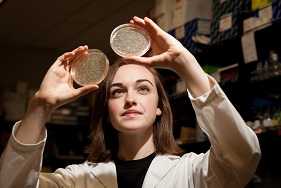

2017 WKU Sisterhood Research Internship Grant
2017 WKU Sisterhood Research Internship Grant Recipients
![]() |
Wendy Cecil WKU, Department of Chemistry Mentor: Dr. Cathleen Webb |
![]() |
Meghan Perez WKU, Department of Biology Mentor: Dr. Rodney King |
Some of the links on this page may require additional software to view.